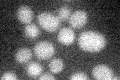
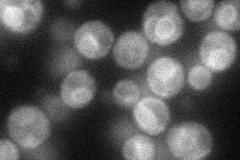
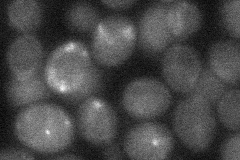

View description
Low-affinity amino acid permease, may act to supply the cell with amino acids as nitrogen source in nitrogen-poor conditions; transcription is induced under conditions of sulfur limitation; plays a role in regulating Ty1 transposition
Localization:
Intensity:
Fold change:
Significance:
-
C’ GFP library in SD
below threshold16.39 -
N' NOP1pr-GFP in SD
ER56.0688 -
N' TEF2pr-mCherry in SD

ER11.7179 -
N' NATIVEpr-GFP in SD

below threshold17.5709 -
N' TEF2pr-VC and Cyto-VN in SD
below threshold26.4167 -
C’ GFP library in SD+DTT

cytosol14.640.89No -
C’ GFP library in SD+H2O2

cytosol16.471No -
C’ GFP library in Starvation Media

cytosol21.281.29No -
C’ GFP library on the background of Pup2-DaMP

below threshold -
C’ GFP library on the background of CCT mutant

below threshold15.13040.922696No
